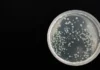
В Бургас спасиха жена от бактерия, която убива за часове

Жертвата е ударена с каменна плоча по главата
Извършено е жестоко убийство в района на столичния кв. Бояна, съобщиха от полицията.
Около 15:20 часа в полицията е получен сигнал за намерена жена в безпомощно състояние. На място незабавно са изпратени екипи на полиция и Бърза помощ. Констатирана е смъртта на жената.
Според първоначалните данни от огледа жертвата е ударена с каменна плоча по главата.
Столични криминалисти работят по изясняване на всички факти и обстоятелства около трагичния инцидент.